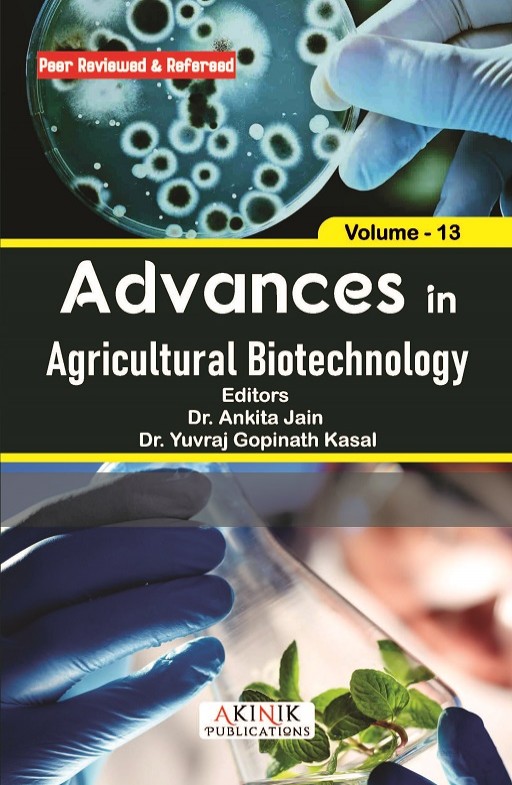
Advances in Agricultural Biotechnology (Volume - 13)

| Editor(s) | : | Dr. Ankita Jain and Dr. Yuvraj Gopinath Kasal |
| Paperback ISBN | : | 978-93-7150-745-5 |
| Ebook ISBN | : | 978-93-7150-292-4 |
| Publisher | : | AkiNik Publications |
| Language | : | English |
| Pages | : | 208 |
| Publication Year | : | 2026 |
| Binding | : | Paperback |
| DOI | : | https://doi.org/10.22271/ed.book.3502 |



The structural coherence of this book is exemplary, guiding the reader through complex material with remarkable lucidity. The arguments are presented in a logically unfolding sequence, ensuring accessibility. This work is a paradigm of scholarly clarity.